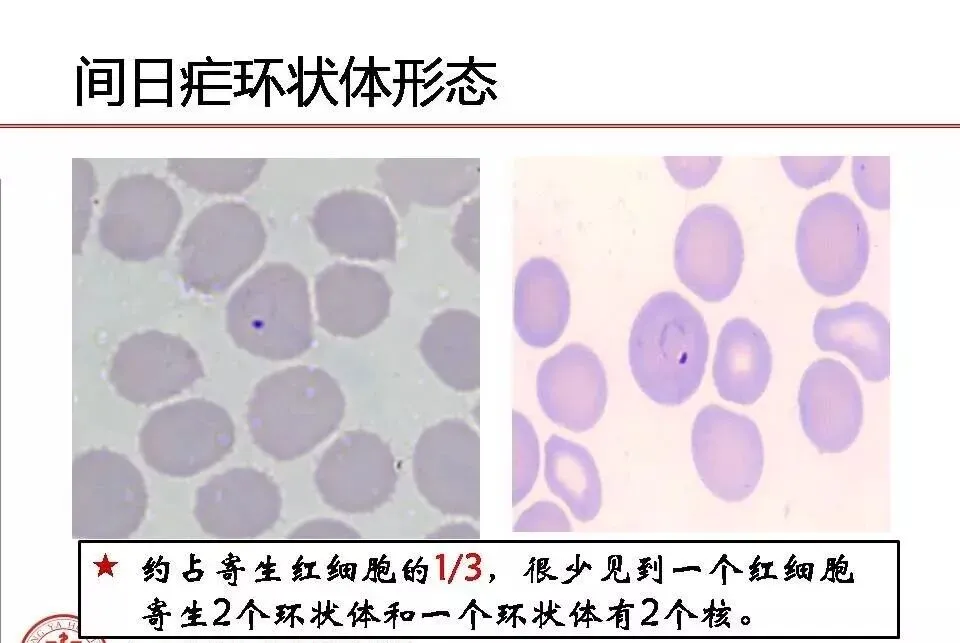
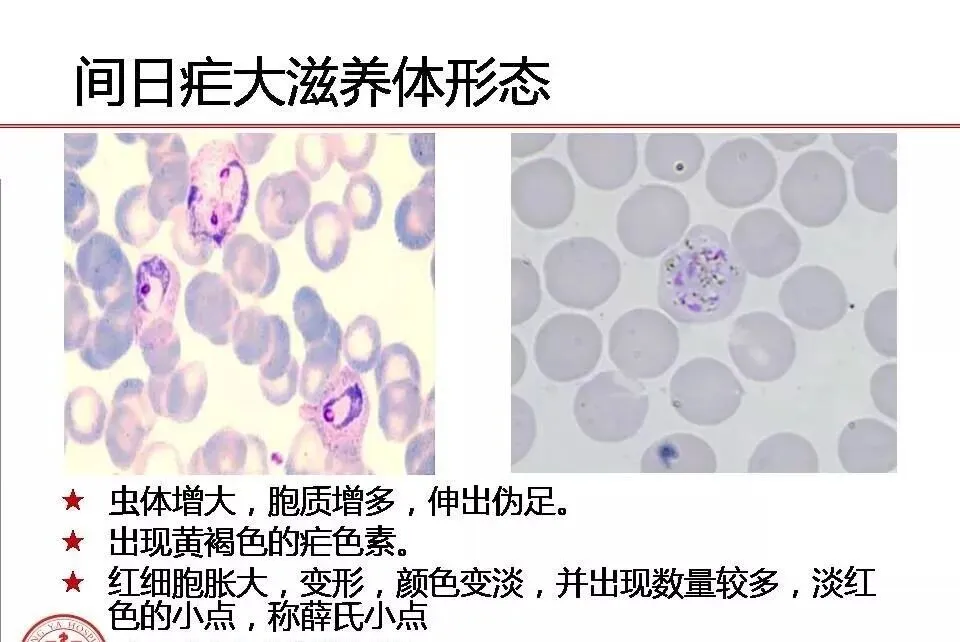
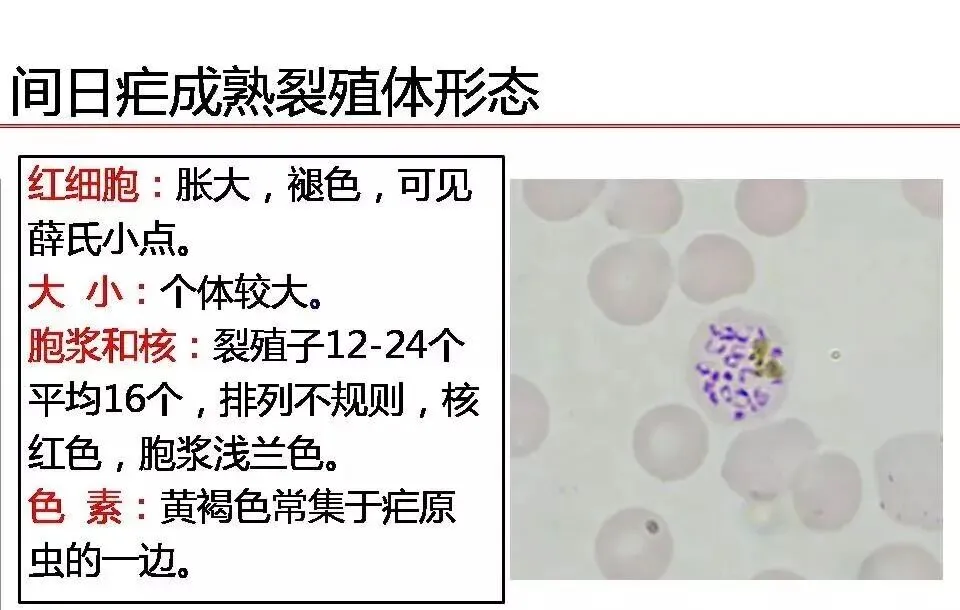
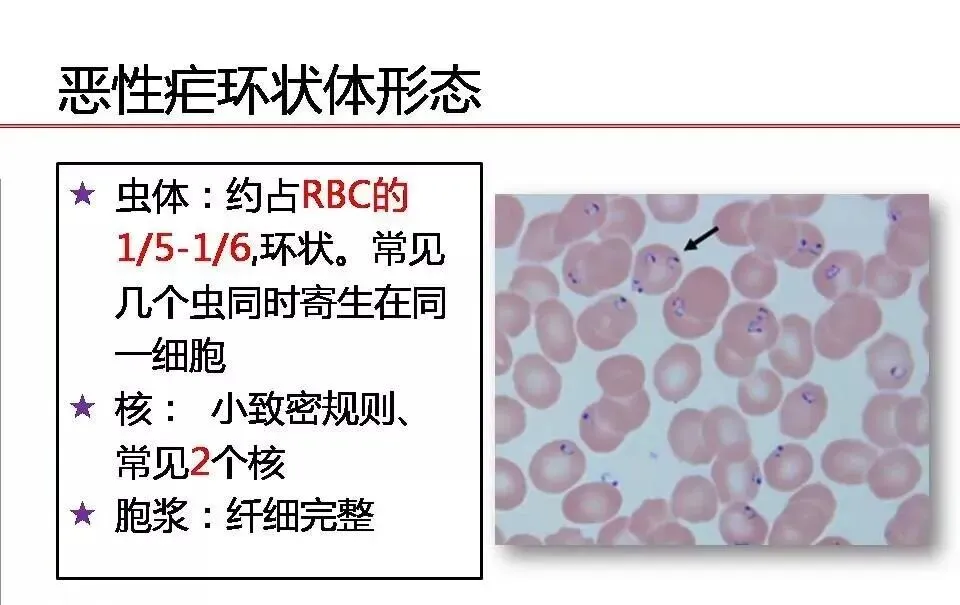
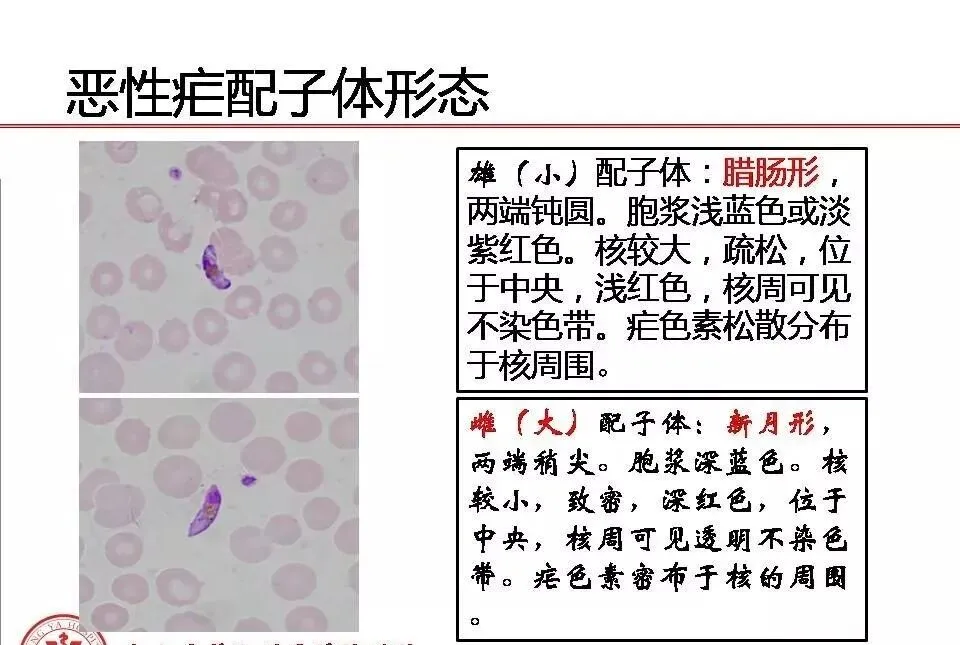
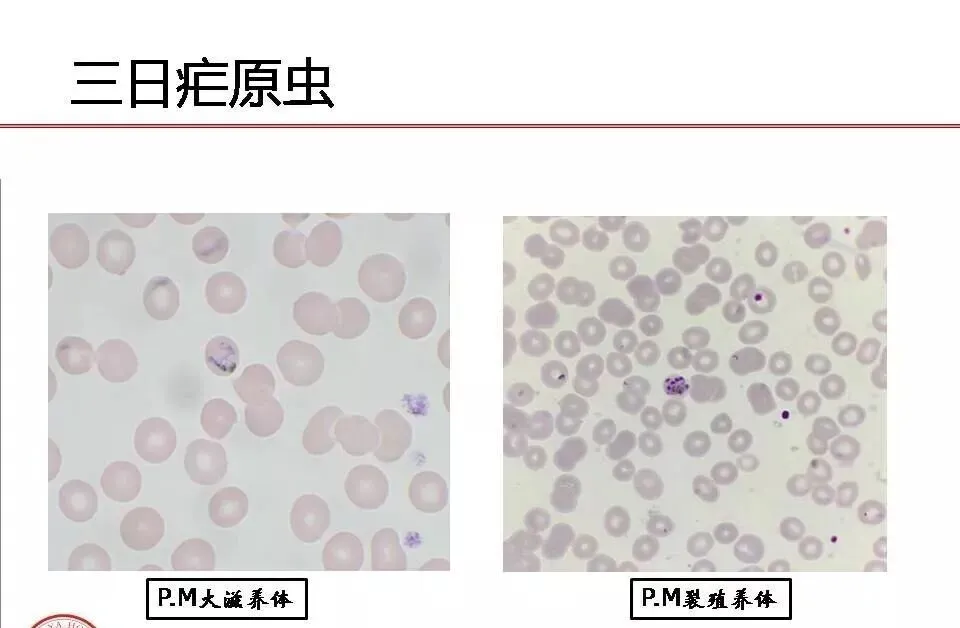
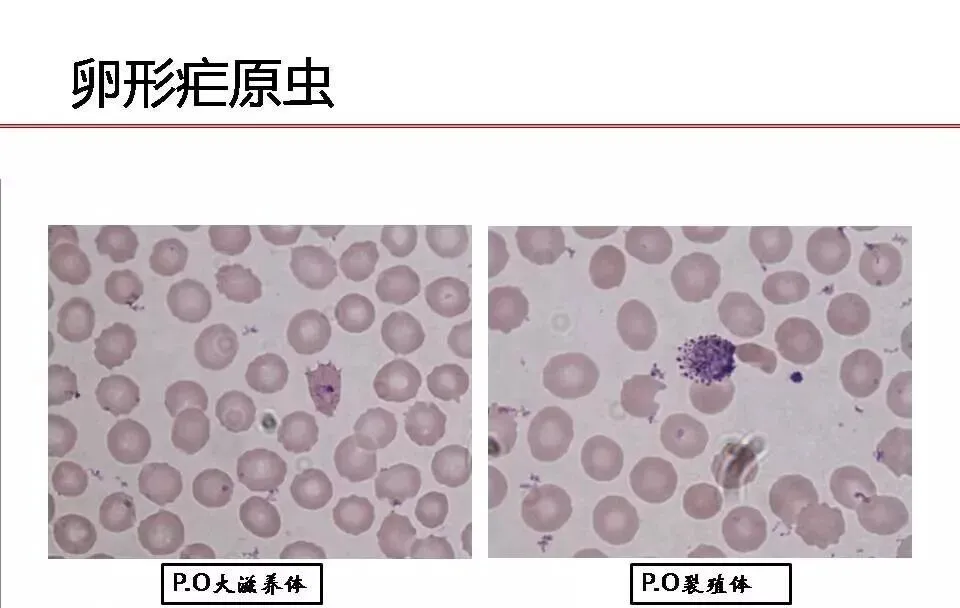

在中国的史书上,对于疟疾多有记载,汉武帝讨伐闽越时期,“瘴疠多作,兵未血刃而病死者十之二三”,清乾隆期间数度进击缅甸都因疟疾而频频受挫,有时竟会“及至未战,士卒死者十已七八”足以证实其为最为流行而又凶险的疾病之一,甚至在很大程度上来说改变了人类历史的演进方向。
2011年9月我国著名药学家屠呦呦教授及其团队发现青蒿素——一种用于治疗疟疾的药物,此举挽救了全球特别是发展中国家的数百万生命。同年,屠呦呦教授获得拉斯克奖和葛兰素史克中国研发中心“生命科学杰出成就奖”2015年10月,屠呦呦教授获得诺贝尔生理学或医学奖,理由是,她发现青蒿素,这种药品可以有效降低疟疾患者的死亡率。为全球抗疟做出重大贡献。那么作为检验工作者,我们来了解下所谓疟疾,如何精准识别吧!
寄生于人体的疟原虫共四种,即恶性疟、间日疟、三日疟、卵形疟。除三日疟原虫偶然寄生于非洲猿类外,其它三种人体疟原虫均为专性寄生于人体。此外,有些猴和猩猩疟原虫也可能偶尔寄生于人体,如食蟹猴疟原虫、食蟹猴疟原虫巴士虫、诺氏疟原虫、豚尾猴疟原虫、巴西疟原虫、艾氏疟原虫、许氏疟原虫和吼猴疟原虫等九种,其中豚尾猴疟原虫、巴西疟原虫和许氏疟原虫可在实验条件下感染人类,其余偶有感染报道。
1、红细胞内发育
血液中的疟原虫裂殖子进入红细胞内,进行裂体增殖。经过数代裂体增殖后,部分裂殖子进入红细胞发育成此配子体或者雄配子体。
2、蚊体内发育
当雌按蚊吸食感染了疟原虫的患者的血液后,疟原虫随血液进入按蚊体内,只有配子体不能被蚊子消化,并发育成雌雄配子。其在蚊子体内受精,形成合子,在发育成合子后,穿过蚊胃壁,形成卵囊,囊内形成许多子孢子,子孢子通过蚊子的血腔进入唾腺,当这种按蚊再次叮咬人体,子孢子同唾液进入人体,重复在体内繁殖。
3、肝细胞内发育
按蚊叮咬人体后,子孢子随血液入侵肝细胞,子孢子在肝细胞内裂体增殖为裂殖体。裂殖体不断增值成裂殖子,后裂殖体破裂,裂殖子散出,一部分被吞噬细胞吞噬,另一部分进入红细胞内进行红细胞内的发育繁殖。
疟原虫目前实验室检验方法学主要分为三类:①以镜检为基础,②以免疫学为基础,③以分子生物学为基础。
镜检技术是疟原虫镜检的金标准,随着我国疟疾的减少,越来越多的检验人员对于疟原虫形态学检验技术已经是日趋生疏,下面简要介绍四种疟原虫的形态特征及鉴别。

四种疟原虫鉴别要点
鉴别点 | 恶性疟 | 间日疟 | 三日疟 | 卵形疟 | |
被寄生 RBC 变 化 | 大小 | 正常或略小 | 大1.5-2倍 | 正常或略小 | 正常或涨大 |
形状 | 除环状体,其余期均涨大 | 多数卵圆形,边缘不整齐 | |||
颜色 | 正常或稍紫 | 褪色,滋养体期出现鲜红色 | 正常 | 褪色 | |
斑点 | 可见3-5个紫红色粗大茂氏点 | 薛氏点鲜红,细小数多 | 偶见纤细的齐氏点,淡蓝紫色 | 薛氏点粗大且多,薛氏点出现较早 | |
环状体 | 大小 | 约为红细胞直径1/6-1/5,环纤细 | 约为红细胞直径的1/3,环较粗大 | 约为红细胞直径的1/3,环较粗 | 约为红细胞直径的1/3 |
核 | 1-2个 | 1个,呈红色,偶有2个 | 1个 | 1个 | |
胞质 | 纤细 | 较薄,淡蓝色 | 较粗厚,深蓝色 | 较粗厚 | |
色素 | 无 | 无 | 偶见细小褐色颗粒 | 无 | |
RBC | RBC多重感染较常见,一般RBC内可见2个以上原虫,虫体位于边缘 | RBC多重感染不多见,一般RBC内含1个原虫,偶有两个,被寄生RBC无变化 | 红细胞的多重感染很少见,一般红细胞内很少见2个原虫 | 似三日疟原虫 | |
图 像 | ![]() |
| ![]() | ![]() | |
大 滋 养 体 | 大小 | 中等大小,一般不出现在外周血,主要集中在内脏毛细血管 | 较大 | 体小 | 体较三日疟原虫大 |
形状 | 很少呈阿米巴圆形,空泡不显著 | 阿米巴样,空泡明显,胞质增多,形状不规则,伪足伸出 | 袋状非阿米巴样,空泡小或无 可呈大环状 | 圆形,空泡不显著 | |
核 | 1个或2个 | 1个,较大 | 1个 | 1个 | |
色素 | 黄褐色,细小,短杆状,细小分布 | 早期疟色素细小,金黄色,晚期结成块状,黑褐色 | 较粗大,深褐色,常沿虫体边缘分布 | 棕黄色,较粗大 | |
图 像 | ![]() |
| ![]() | ![]() | |
裂殖体前 期 | 大小 | 较小 外周血看不到 | 较大 | 较小,小于正常RBC | 较小 |
形状 | 圆形,空泡消失 | 圆形或不规则,空泡消失 | 圆形,空泡消失 | 圆形或卵圆形,空泡消失 | |
核分裂数 | 2个以上 | 2个以上 | 2个以上 | 2个以上 | |
色素 | 疟色素集成团块,黑褐色 | 疟色素开始集中,黄褐色,分布不均 | 疟色素集中较迟,深褐色,且分布不均 | 疟色素集中较迟,棕黄色,分布不均 | |
图像 | ![]() | ![]() | ![]() | ![]() | |
成 熟 裂殖体 | 大小 | 小于正常红细胞 | 大于正常红细胞 | 小于正常红细胞 | 小于正常红细胞 |
裂殖子 | 在外周血中看不到,8-36个,通常18-26个 | 虫体充满涨大的RBC,裂殖子12-24个,常16-18个,排列不规则,常聚集一侧 | 裂殖子较大6-12个,常8个,排列成菊花状 | 似三日疟原虫,但裂殖子稍大,排列不规则,6-12个,常8个 | |
色素 | 黑褐色,呈团块状 | 黄褐色,集成一堆或两堆 | 深褐色,粗大集于中央 | 棕黄色基于中央或一侧 | |
图像 | ![]() | ![]() | ![]() | ![]() | |
雌 配子体 | 大小 | 较大 | 大于正常RBC | 小于正常RBC | 小于正常RBC |
形状 | 新月形,两端较尖 | 圆或卵圆形 沾满涨大RBC | 圆形 | 圆形 | |
胞质 | 深蓝色 | 深蓝色 | 深蓝色 | 深蓝色 | |
核 | 1个,较小,深红色,位于中央 | 1个,致密 较小,深红色,偏向一侧 | 1个,较小,深红色,偏于一侧 | 1个,较小,深红色,偏于一侧 | |
色素 | 黑褐色,紧密分布在核周围 | 黄褐色,均匀散在于胞浆中 | 深褐色,多而分散 | 棕黄色,分散 | |
图像 | ![]() | | ![]() | ![]() | |
雄 配子体 | 大小 | 较大 | 大于正常RBC | 略小于正常RBC | 小于正常RBC |
形状 | 腊肠样,两端钝圆 | 圆形 | 圆形 | 圆形 | |
胞质 | 浅蓝色或浅红色 | 淡蓝色或淡红色 | 浅蓝色 | 浅蓝色 | |
核 | 1个,较大,疏松,淡红色,位于中央 | 1个,较大,疏松,浅红色,位于中央 | 1个,较大,疏松,淡红色,位于中央 | 1个,较大,疏松,淡红色,位于中央 | |
色素 | 黑褐色,松散分布于核周 | 黄褐色,均匀散在核周 | 深褐色,均匀散在核周,较粗大 | 棕黄色,散在 | |
图像 | ![]() | | ![]() | |
胶体金试剂的检验原理为:采用免疫层析分析技术和双抗体夹心法检测全血样本中的特异性恶性疟原虫乳酸脱氢酶(pfLDH)以及普通型疟原虫乳酸脱氢酶(panLDH),如果样本中含有恶性疟原虫乳酸脱氢酶(pfLDH)以及普通型疟原虫乳酸脱氢酶(panLDH),将会与胶体金标记物中所含有的普通型疟原虫乳酸脱氢酶单克隆抗体反应形成抗原抗体结合的免疫复合物,在层析作用下前移,被预先固定在硝酸纤维素膜上的检测区内的恶性疟原虫乳酸脱氢酶(pfLDH)或者普通型疟原虫乳酸脱氢酶(panLDH)单克隆抗体捕获,在检测区形成1条/2条抗原抗体反应的红色条带反应线,此时可以判断结果为阳性结果;若样本中不含有恶性疟原虫乳酸脱氢酶(pfLDH)以及普通型疟原虫乳酸脱氢酶(panLDH),则在检测区不会产生红色反应线,可判断为结果阴性,为了判断样本是否足量、层析过程是否正常,设置一条C线,即质控线。其原理为无论待检测物质是否存在,胶体金标记物疟原虫乳酸脱氢酶(panLDH)抗体都会与硝酸纤维素膜上质控区内预包被的抗鼠免疫球蛋白G(IgG)多克隆抗体反应,形成红色质控条带。该检测方法学最低检测限为100个疟原虫/ul,但当样本中类风湿因子浓度较高时,会存在干扰试验结果。

分子方法在低密度疟原虫感染水平的检测更为敏感,并且可以确定虫种。其根据疟原虫小亚单位核糖体核糖核酸(SSUrRNA)基因和Pfs25基因等的保守序列设计引物和探针,来检测疟原虫感染。根据四种感染人的疟原虫的18SrRNA基因序列,设计属、种特异性引物和TaqMan探针,用荧光定量PCR技术检测标本的基因拷贝数,并用电泳区别各种疟原虫,阳性标本有特征性扩增曲线,且Ct值与基因含量的对数logC0呈良好的线性关系,对产物进行琼脂糖凝胶电泳可检测到特定长度片段,可以此鉴别虫种。
据相关文献报道,传统镜检方法学廉价可靠,至今仍是疟疾诊断的金标准,但对于一些低流行区、低浓度疟原虫感染者、镜检人员技术等因素易造成漏诊及误诊,但基层医院PCR方法受多种因素影响难以开展,笔者建议镜检技术联合胶体金技术同时检测,值得临床推广和使用,尤其是基层医院疟原虫筛检工作的开展。
检验医学是循证医学的有机基础,是转化医学的重要组成,是精准医学的核心部分。单打独斗已成为历史,外科微创化、内科外科话、检验临床化、MDT多学科合作已成趋势。检验离开临床没有出路,临床离开检验只剩归途。近年来检验医学新技术日新月异,检验的学术地位和临床价值与日增高,为临床精准诊断提供有力保障。虽然我国疟疾本发性已经很少,但输入性疟疾形势依然严峻,这就要求我们检验人,牢记检验人使命,不忘检验初心,通过加强疟原虫检验理论与技术相结合,为十分凶险的疟疾诊断尽早提供依据,作者通过目前疟原虫检验的主要技术进行分类汇总,让大家重新对疟原虫检验技术有了新的认知,我们在以后工作中也要充分考虑形态学及免疫学检验的独立性和互补性,做到融会贯通、举一反三,时刻与临床保持高效沟通,为临床疾病的精准诊断保驾护航,用我们的实力展现检验的神奇和魅力。
侯卫科,毕业于郑州大学检验医学专业,硕士,副主任技师,现任河南宏力医院检验科副主任,先后在济宁医学院附属医院及北京协和医院进修实验室管理及临床检验专业。先后荣获河南宏力医院杰出贡献奖、长垣优秀共产党员、长垣卫生先进工作者、长垣优秀知识分子、长垣拔尖技术人才等荣誉。现任中华医学会委员、河南省医院管理委员会检验学会常委、河南省中西医学会检验分会委员、河南省自身免疫学会委员、河南省微生物学会委员、先后发表国家级论文20余篇,科技核心期刊5篇,获科技进步奖一项。
参考文献:
1.World HealthOrganization.NewPeHpecfives:MalariaDiagnosis.J0intWHO/USAIDinformal consultation.Geneva:WorldHealthOrganization。2000.
2.Moody A.Rapiddiagnostic tests for malaria parasites.ClinMiembiolRev.2002,15:66-78.
3.徐隆祺.图说寄生虫学与寄生虫病 北京:北京医药出版社2016.6:241-260
4.万向阳.孙菲李欢 荧光定量PCR技术在疟疾诊断中的应用[J].实用预防医学2014.21(1):127-129